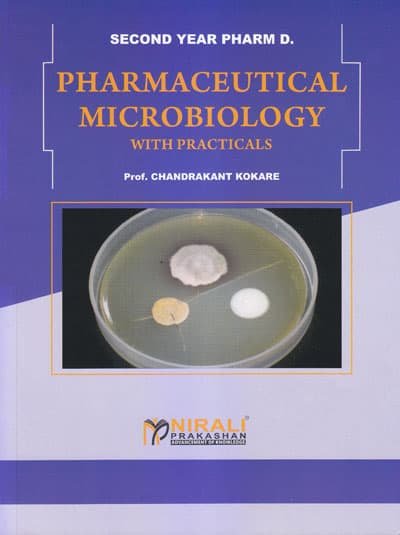
PHARMACEUTICAL MICROBIOLOGY WITH PRACTICALS

Pharm D Textbooks - Professional Pharmacy Doctorate Course
35 titles found

PHARMACOLOGY I
1 General pharmacology 2 Pharmacology of drugs acting on ANS 3 Pharmacology of drugs acting on cardiovascular system 4 Pharmacology of dr...
PHARMACEUTICAL MICROBIOLOGY WITH PRACTICALS
1 Introduction 2 Classification of Microbes 3 Growth and Cultivation f Microbes 4 Isolation and Identification of Bacteria 5 Sterilizati...

PRACTICAL MANUAL - PHARMACOGNOSY AND PHYTOPHARMACEUTICALS
1 Microscope and instructions to use pharmacognosy laboratory 2 Study of cell wall constituents and cell inclusions 3 Macro powder and mic...

HUMAN ANATOMY AND PHYSIOLOGY (First Year (FY) Pharm. D.)
1 Introduction to human body 2 Structure of cell 3 Elementary tissue of human body 4 Osseous system 5 Classification of Joints 6 Haemop...

A PRACTICAL BOOK OF REMEDIAL BIOLOGY
Experiment 1 : Introduction to Biology Experiments Experiment 2 (A) : Study of Cell Wall Constituents , (B) : Study of Cell Inclusions Exp...

A PRACTICAL MANUAL OF PHARMACEUTICS
1 Syrups 2 Elixirs 3 Linctuses 4 Solutions 5 Liniments 6 Suspensions 7 Emulsions 8 Powders 9 Suppositories 10 Incompatibilities
REMEDIAL BIOLOGY
1 Introduction and relevance of biology to pharmaceutical sciences 2 History of biology 3 Modern concepts of biology 4 General organizati...
REMEDIAL MATHEMATICS
1 Determinants 2 Matrices 3 Sides and Angles of a Triangles 4 Solution of Triangles 5 Points 6 Straight Line 7 Circle 8 Parabola 9 L...

COMMUNITY PHARMACY FOR NEW AGE PHARMACIST
1 Community pharmacy practice 2 Community pharmacy 3 Handling prescription and medication errors 4 Patient councilling 5 Patient medicat...
PHARMACEUTICS FOR PHARM. D
1 Profession of Pharmacy 2 Pharmacopoeias 3 Prescription 4 Posology 5 Weights Measures and Pharmaceutical Calculation 6 Dosage Forms 7...

